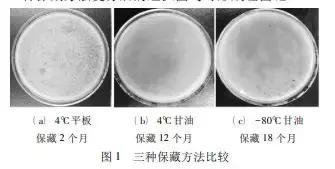
噬菌蛭弧菌怎么活化,噬菌蛭弧菌活力检测方法

20 世纪60 年代,Stolp 和 Petiold 首次分离得到了蛭弧菌。它广泛分布于自然水域、污水和土壤中,是一类专门以捕 食细菌为生的寄生性细菌,可以有效裂解水体中的一些病原菌,同时还可以缓解水体中一些有害物质的影响,并且对鱼类致病菌有明显的裂解作用,因此可利用该特性来防止水产动物的病害,其微生物生态制剂在水产养殖方面也发挥了较大的作用。
噬菌蛭弧菌是一类可以寄生于其他细菌并使其裂解的革兰氏阴性细菌,因此,在半固体和固体介质中蛭弧菌侵噬宿主菌后会形成类似于病毒感染细胞后形成的空斑。为了进一步探究蛭弧菌 “活抗生素”的可行性,并进一步了解蛭弧菌的特性,菌种保藏方法就显得极为重要。通常实验室采取 4℃ 平板保藏法来保藏菌种,该方法不但操作简单,且复活率达到100%,但是这种方法一般只能保藏 4 个月左右,4个月后培养基就会严重脱水变干,需要不断活化转种来保持它的生物学活性。因此该方法耗时繁琐不适合长期保存。为了方便实验,找到一种既可以延长蛭弧菌保藏时间又较为简便的方法尤为重要。而关于蛭弧菌的保藏方法,国内外的研究比较少,且各实验室报道结果各异。
1963年文献提出了在含有宿主细胞的YP琼脂中保藏蛭弧菌,每月转种一次的培养方法。2002年文献为了探究蛭弧菌在水产养殖方面的作用,曾利用蛭弧菌 Bd-9进行5种保藏方法及其存活效果的观察实验,其结论为冷冻干燥法保藏效果最好,21个月的复活率高达100%,其次为4℃营养肉汤液保藏法和-20℃甘油保藏法,17个月复活率均为 67%。 2008 年文献发现以1 /100 NB 等低营养液体为保护液,琼脂为载体,加入适量宿主菌后保存于4℃,蛭弧菌保藏可达两年以上。而在国际上,公认的长时高效的保藏蛭弧菌菌株的方法有冷冻真空干燥法和液态氮超低温两种。这两种方法虽然有效,但其操作繁琐,成本高昂。其他一些简单易行的方法,如自来水宿主软琼脂保藏蛭弧菌培养物方法,虽然简单,但保藏时间较短且效果差。因此为了寻找一种更为简单高效的保藏方法,本文采用了-80℃甘油保藏法、4℃ 平板保藏法和4℃甘油保藏法这三种方法对实验室培养的蛭弧菌进行保藏处理,并筛选出最佳保藏方法为-80℃甘油保藏法。该方法的建立不仅简单快捷, 而且降低了实验成本,同时也为继续开展蛭弧菌相关实验奠定了基础。
1 实验材料
1.1 试验菌种; 宿主菌为大肠埃希氏菌。
1.2培养基及试剂宿主菌培养基为液体 LB 培养基。蛭弧菌培养基为双层培养基,上层为 0.4%琼脂 LB 半固体培养基,下层为 2%琼脂培养基。
1.3主要仪器及试剂 GR85DA 全自动灭菌锅购自 Zeaway,1300系 列-A2 生物安全柜购自美国 Thermo,SHP-080生化培养箱购自上海精宏,Micro-17离心机购自美国 Thermo。甘油由市面上购买所得,121℃ 灭菌 20 min; 生理盐水 ( 0. 85%) 121℃灭菌 20 min。
2 实验方法
2. 1 制备宿主菌菌悬液
勾取斜面培养基上的大肠杆菌菌体至液体 LB 培养基中,37℃ 震荡培养过夜,置于 4℃ 冰箱中备用。
2. 2 蛭弧菌纯液的制备
取已长有较大蛭弧菌单斑的双层平板,按无菌操作要求,用火焰灭菌的接种环挑取蛭弧菌单斑浸泡于装1 mL灭菌生理盐水的EP管中,捣碎混匀后 10000 g 离心 10 min,用无菌注射器吸取上清液,再用 0. 22 μm 的细菌过滤器去除大肠杆菌, 以获得纯的蛭弧菌菌液。
2. 3 蛭弧菌的保藏方法
2. 3. 1 4℃平板保藏法
将称装有3.5 mL 已加热融化的上层半固体 LB培养基冷却至约 50℃,依次加入 0.2 mL 大肠杆菌 菌悬液和 0.3 mL 蛭弧菌菌悬液,震荡混匀后立即 倾倒于预制好的下层培养基上,待其凝固后置于 28℃恒温培养箱中扩增培养 24~120 h,观察培养皿中菌斑的生长情况。待长出较多的蛭弧菌菌斑后用 封口膜密封好皿口,将培养皿倒置于 4℃ 的冰箱中保藏。
2. 3. 2 4℃甘油保藏法
双层平板法培养蛭弧菌方法同 2. 3. 1 节。当观察到有大量蛭弧菌菌斑出现后,向其中加入10 mL已灭菌的甘油,并用封口膜将培养基密封好后置于4℃的冰箱中保藏。
2. 3. 3 -80℃甘油保藏法
蛭弧菌纯液的制备方法同 2. 2 节。将菌液与甘油以 4∶1 的比例加入 10 mL的灭菌管中,在振荡器上充分摇匀后,用封口膜密封管口。先将混合液置于-20℃的冰箱中预冷 24 h,然后放入-80℃ 的冰箱中保藏。
2. 4 蛭弧菌的复苏实验
取以上 3 种方法保藏的菌种定期进行复苏实验,观察保藏效果。蛭弧菌的复活方法为双层平板培养法。对 4℃平板法保藏的蛭弧菌来说,先将双 层平板的上层刮到灭菌的生理盐水中,并将培养基 尽量捣碎,然后置于 37℃ 下放置 30 min,让更多 的蛭弧菌游离出培养基。按 2. 2 节方法,得到纯的 蛭弧菌菌悬液。再按 2. 3. 1 节方法制成蛭弧菌双层平板,并分别在第 1~第 5 天观察平板上菌斑的形成情况。对于 4℃甘油平板保藏法所保藏的菌种,应先将培养基中的甘油倒掉后再制成菌液,再按上述方法进行试验。对于-80℃ 甘油保藏的菌液,待其恢复室温后便可直接使用,按上述方法制作双层平板以供观察。实验结果出现至少两个蛭弧菌菌斑为阳性,少于两个为阴性。
3 结果与分析
我们对三种不同方法保存的蛭弧菌定期进行复苏实验以检测菌种活性,并做统计。如图 1所示,3 种保藏方法复苏后的蛭弧菌均可形成噬菌斑。
统计结果如表 1 所示。从表 1 中可以看到,采用 4℃平板保藏方法时蛭弧菌可保存 1~2 个月; 4℃ 甘油保藏法可保藏 11~12 个月; 效果最好的是-80℃甘油保藏法,连续保藏 18个月后,蛭弧菌仍保持较高的活性。


4 结束语
蛭弧菌是一类可以通过细菌滤器并寄生于多种有害细菌并导致其裂解的革兰氏阴性细菌,有望成为“活抗菌素”,因此也被认为是自然净化的生物因子之一。 本文使用同一种蛭弧菌及同一种宿主菌,对蛭弧菌的 3种保藏方法进行了比较。结果发现-80℃ 甘油保藏法保藏时间可长达 18 个月,复苏后不仅 第一代活性较高,而且第二代和第三代活性仍然较 好。该方法不仅需要的仪器设备简单,操作步骤十分简便,而且不需要频繁接种。因此,该方法为蛭弧菌相关实验奠定了基础。